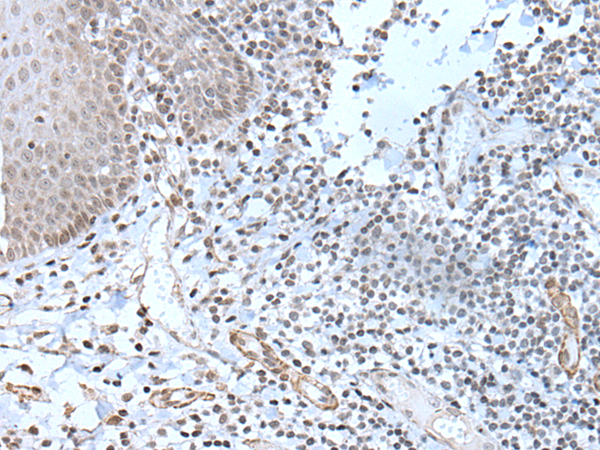

中文名稱: 兔抗ZBTB11多克隆抗體
技術(shù)規(guī)格
Background:
The Zinc finger and BTB domain-containing protein 11 (ZBTB11) contains 1 BTB (POZ) domain and 12 C2H2-type zinc fingers suggesting a role in transcription regulation. The gene encoding ZBTB11 maps to chromosome 3, which contains over 1,100 genes. Notably, a chemokine receptor gene cluster and a variety of human cancer related loci reside on chromosome 3. Particular regions of the chromosome 3 short arm are deleted in many types of cancer cells as well.
Applications:
ELISA, IHC
Name of antibody:
ZBTB11
Immunogen:
Synthetic peptide of human ZBTB11
Full name:
zinc finger and BTB domain containing 11
Synonyms:
ZNF913; ZNF-U69274
SwissProt:
O95625
ELISA Recommended dilution:
5000-10000
IHC positive control:
Human prostate cancer and human tonsil
IHC Recommend dilution:
10-50

購物車
購物車 幫助
幫助
 021-54845833/15800441009
021-54845833/15800441009
